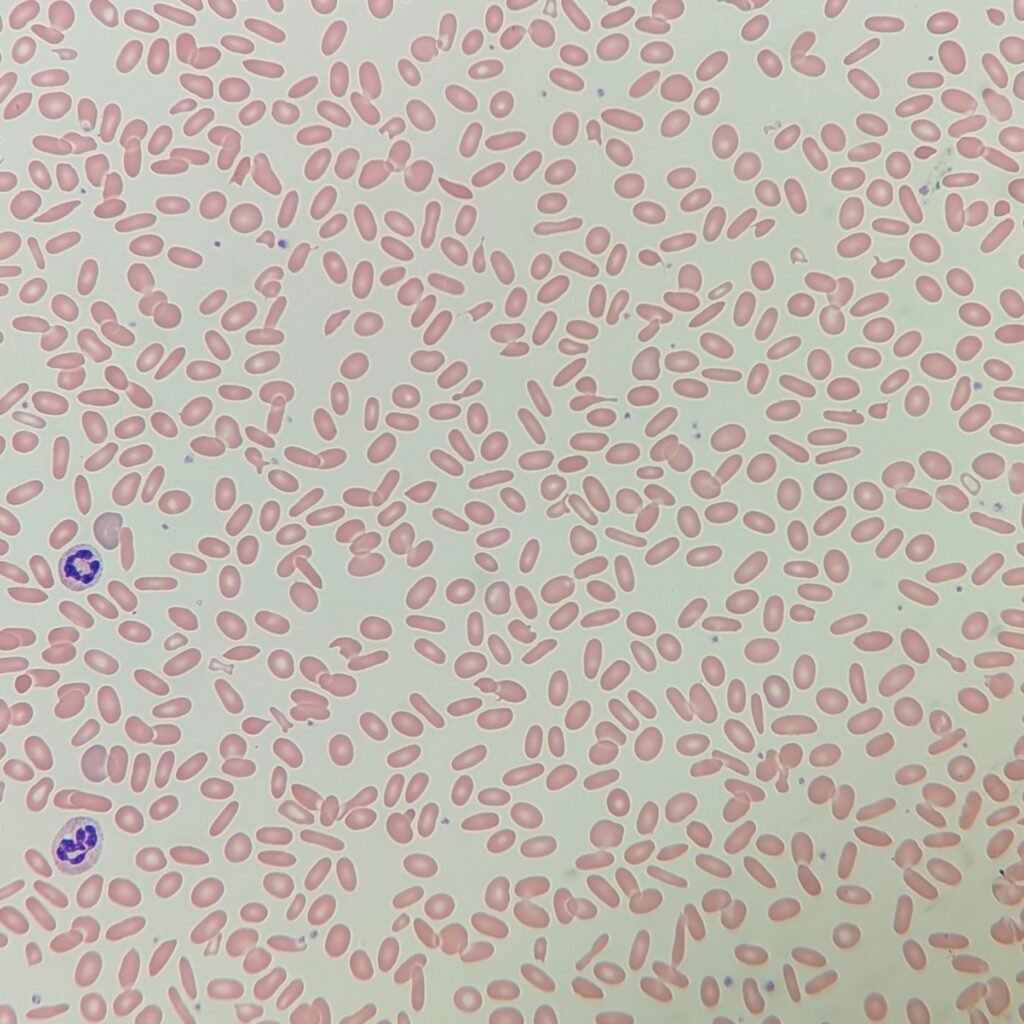
Elliptocytes/Ovalocytes, red blood cell morphology
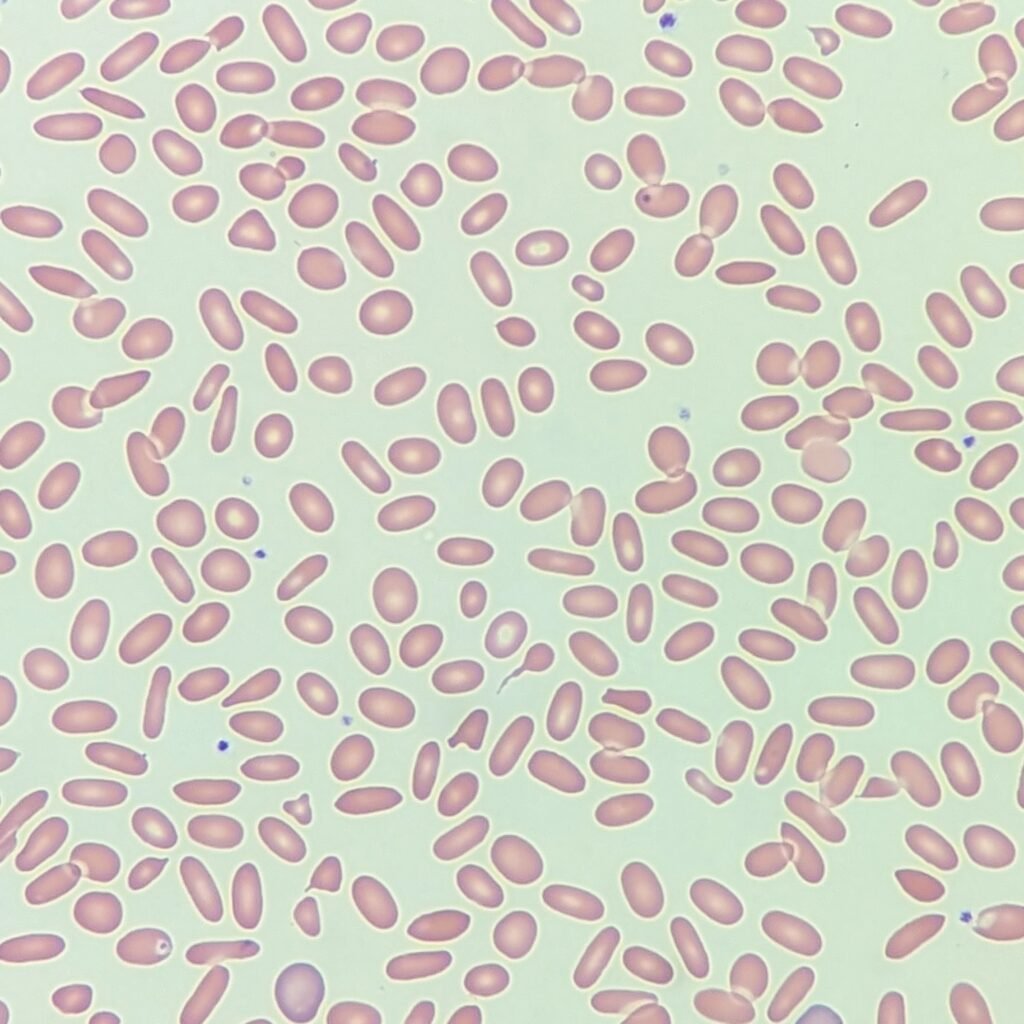
Elliptocytes/Ovalocytes, red blood cell morphology
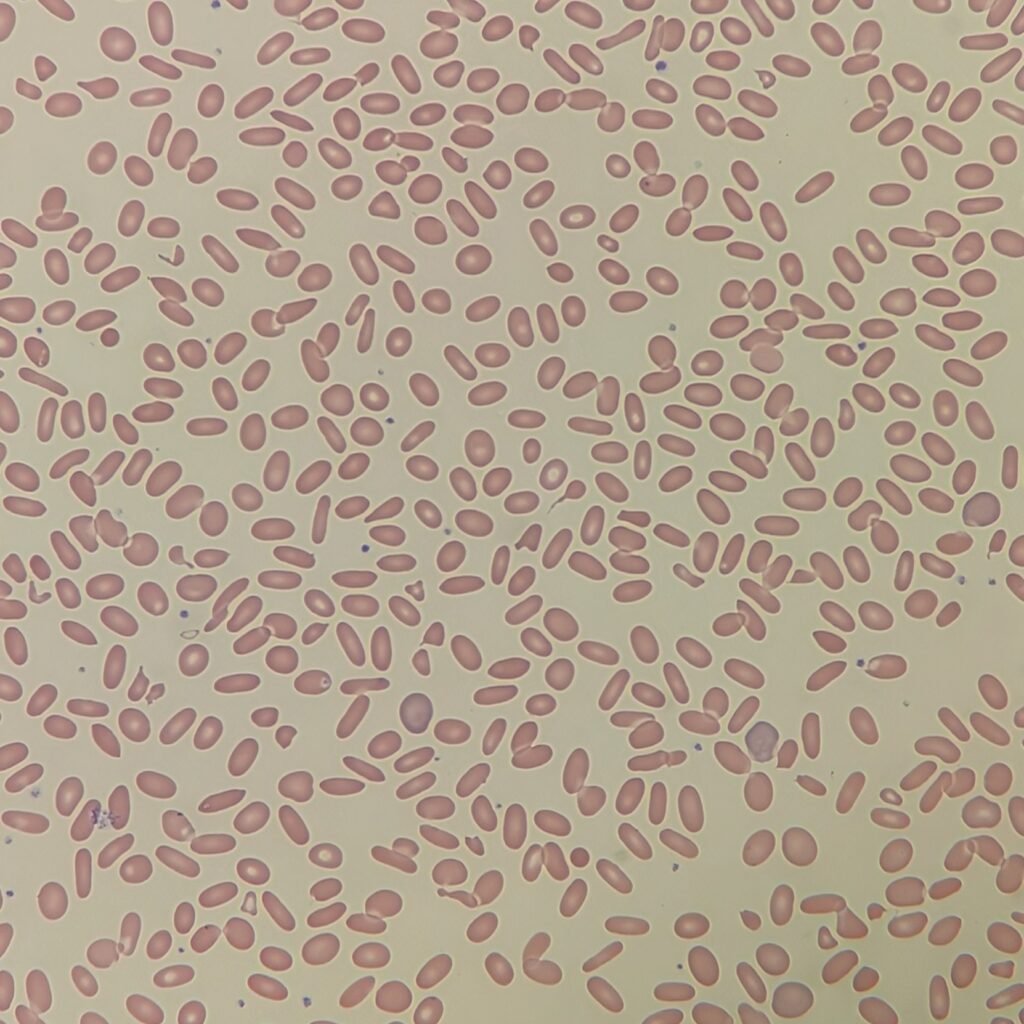
Elliptocytes/Ovalocytes, red blood cell morphology

Elliptocytes and ovalocytes are often lumped together in red blood cell morphology. Elliptocytes can be seen in hereditary elliptocytosis due to a defect in the membrane. Macroovalocytes specifically are seen in megaloblastic anemias.
Otherwise, ovalocytes are seen in myelofibrosis, iron deficiency anemia, and thalassemia.
Appearance
Ovalocytes are typically more egg-shaped while elliptocytes are skinnier and more pencil shaped. However, the two terms are often used interchangeably.

Lookalikes
Elliptocytes may be mistaken for sickle cells, as they are both thin. However, sickle cells will have sharp edges and lack central pallor. Sickle cells are usually also crescent-shaped.
Quick Summary
- Morphology/Appearance:
- Elliptocytes: Pencil-Shaped
- Ovalocytes: Egg-Shaped
- Macroovalocytes: Large ovalocytes
- Clinical Significance:
- Elliptocytes: Hereditary Elliptocytosis
- Ovalocytes: Myelofibrosis, Iron Deficiency Anemia, Thalassemia
- Macroovalocytes: Megaloblastic Anemias
- Common Lookalikes
- Sickle Cells which lack central pallor and have sharp edges
Gallery